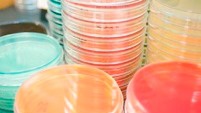
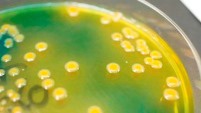

検査部
検査部について
分析情報から病態情報へ
早期診断、より進んだ病体解析を求めて新しい可能性への挑戦を行っています。
【スタッフ】
| 臨床検査技師 | 18名(パートタイム職員4名含む) |
【臨床検査技師 資格取得状況】
| 日本糖尿病療養指導士 | 2名 |
| 国際細胞検査士 | 2名 |
| 細胞検査士 | 2名 |
| 認定超音波検査技師 | 2名 |
| 認定心電検査技師 | 1名 |
| 認定病理検査技師 | 1名 |
| 栄養サポートチーム(NST)専門療法士 | 1名 |
| 消化器内視鏡技師 | 2名 |
| 心血管インターベンション技師 | 1名 |
| 緊急検査士 | 2名 |
| 特定化学物質及び四アルキル鉛等作業主任者 | 2名 |
| 有機溶剤作業主任者 | 1名 |
| 日本乳がん検診制度管理中央機構(B) | 1名 |
| 2級甲類臨床病理技術士 | 1名 |
| 2級臨床検査士(微生物学) | 1名 |
【施設認定】
日本臨床細胞学会認定施設
検査室のご紹介
採血室
4台の採血台で臨床検査技師と看護師が採血を行っています。

血液検査室
採血した血液の成分を様々な自動分析器で測定しています。
これらの数値は身体の状態をよく反映します。得られた数値に臨床検査技師の目を通し、病気の診断・治療の効果を確認するための有効で正確な情報としています。



尿・便検査室
尿の蛋白や糖などの成分は機械で測定し、尿中の細胞や結晶は検査技師が顕微鏡で確認しています。また、便中の潜血や虫卵などの検査も行っています。


病理検査室
喀痰や分泌物、体腔液などの中からがん細胞を探し出す細胞診を行っています。また、身体から採取されてきた様々な組織について、異常の有無を見る組織診も行っています。




細菌検査室
患者さんから採取されるさまざまな材料(便・痰・尿など)の細菌について調べています。
患者さんから得られた検体(痰・尿・便・血液など)を染色し、顕微鏡を用いて病原菌の推定を行います。また、検体中の細菌を専用の培地で培養し、発育した菌の菌種を決め、抗菌薬の効き目があるかどうかを検査します。

生理学検査室
生理検査とは、患者さんの心臓や脳などの働きを電気的にとらえて波形として表したり、体の内部の状態を超音波などを利用して画像にし、観察する検査です。
当院では主に次の検査を行っています。
循環機能検査
- 12誘導心電図
- 運動負荷心電図
- ホルター心電図(24時間心電図)
- 血圧脈波検査
- 24時間血圧記録検査
脳神経系検査
- 脳波
- 神経伝導速度検査
超音波検査
- 心臓超音波検査
- 頸動脈超音波検査
- 下肢動静脈超音波検査
肺機能検査
- 一般検査(肺活量、一秒率)
- 精密検査(機能的残気量、肺拡散能、気道可逆性
- 睡眠時無呼吸検査(簡易型)







